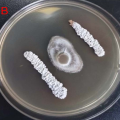
Isolation, identification, and whole-genome sequencing of Streptomyces rochei FE-3-1 against Pyricularia oryzae.

Beauveria Endophytes Can Supercharge Tomato Growth and Block Gray Mold
A newly published study in Journal of Fungi has demonstrated that several species of the entomopathogenic fungal genus Beauveria—long recognized for insect control—also function as powerful endophytes that enhance tomato growth and protect plants from Botrytis cinerea. The research expands the scientific understanding of Beauveria beyond the widely studied B. bassiana, revealing major untapped diversity among lesser-known species.
Five Beauveria Species Successfully Colonize Tomato
The researchers evaluated five species:
- B. bassiana
- B. brongniartii
- B. aranearum
- B. amorpha
- B. velata
Using root-drench inoculation, all species established endophytic colonization in tomato tissues. Colonization rates ranged from 33.3% to 56.7%, with B. brongniartii showing the highest success.
Growth Promotion Varies by Species
Three species—B. bassiana, B. brongniartii, B. aranearum—significantly increased plant height, while B. brongniartii additionally boosted aboveground biomass.
All Species Reduced Gray Mold; One Provided Complete Protection
In pathogen challenge experiments, all Beauveria-treated plants showed reduced disease incidence and severity, demonstrating strong suppression of B. cinerea. Remarkably:
B. brongniartii achieved complete protection—0% disease incidence.
In vitro assays also showed fungal antagonism directly inhibiting B. cinerea growth.
Transcriptomics Reveals the Mechanisms Behind Protection
High-resolution transcriptome analysis revealed:
- 160 core differentially expressed genes shared among all treatments
- 17 commonly upregulated defense-related genes, including protease inhibitors, wound-response genes, and calcium signaling components
- Strong enrichment in pathways related to defense activation, photosynthesis, and stress signaling
These molecular changes align with the observed boost in plant immunity and growth.
A Promising Future for Sustainable Agriculture
The authors conclude that several Beauveria species—particularly B. brongniartii—are promising candidates for next-generation bio-inoculants. Their combined abilities to promote growth and suppress pathogens open new opportunities to reduce reliance on chemical pesticides.
Reference
Chang, Y., Lin, X., Sui, J., Li, Q., Zhao, Y., Sui, L., & Zhang, Z. (2025). Endophytic Beauveria spp. Enhance Tomato Growth and Resistance to Botrytis cinerea via Transcriptomic Regulation. Journal of Fungi, 11(11), 799. https://doi.org/10.3390/jof11110799